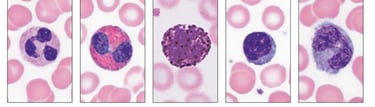

Curso VIP de Limpeza de pele
Sua expertise em seu sucesso profissional
Bem vindo ao Curso VIP de Hematologia Aplicada I: da amostra ao laudo
Por que fazer este curso:
✔ Porque quem domina hematologia tem vantagem profissional imediata: Hematologia é uma das áreas mais exigidas no laboratório clínico, e profissionais que sabem identificar células e realizar contagens são altamente valorizados. Ter uma fluência em todas as etapas do processo vai te proporcionar uma excelente vantagem no mercado de trabalho.
✔ Porque o curso é prático e direto ao ponto: Você aprende exatamente o que precisa para atuar no dia a dia, sem enrolações.
✔ Porque a base da hematologia é essencial para concursos, estágios, empregos e especializações: O domínio da morfologia celular diferencia seu currículo.
✔ Porque você terá contato com técnicas fundamentais — e muitas vezes negligenciadas — do hemograma.
✔ Porque o primeiro lote está aberto com vagas limitadas e condições especiais.
💡 Inscreva-se agora e esteja à frente na confecção de laudos em hematologia!


Conteúdo programático:
1. Introdução à Hematologia
Funções do sangue
Componentes e características
2. Hematopoiese
Órgãos hematopoiéticos
Formação das séries celulares, precursores e maturação
3. Série Vermelha
Eritrócitos normais
Alterações morfológicas
Inclusões eritrocitárias
4. Série Branca
Neutrófilos, eosinófilos, basófilos, linfócitos e monócitos
Células jovens e atípicas, reconhecimento de blastos
5. Série Plaquetária
Morfologia, anormalidades, artefatos comuns
Protocolos, evidências e estratégias para uma prescrição segura, eficaz e baseada em ciência
O Curso Hematologia Aplicada I: Da Amostra ao Laudo foi pensado para estudantes e profissionais das áreas biomédica, laboratorial, enfermagem, farmácia, biologia e todos que desejam desenvolver domínio técnico sobre o sangue, suas células, métodos de contagem e interpretação dos achados laboratoriais. Este curso foi desenvolvido para oferecer uma formação sólida, prática e objetiva aos estudantes e profissionais das áreas de saúde que desejam dominar a base da hematologia e compreender cada etapa do processo que envolve o hemograma. Este curso reúne os fundamentos essenciais para quem busca atuar com segurança no laboratório, desde o manuseio adequado da amostra até a interpretação inicial dos achados laboratoriais.
Durante o curso, o aluno aprenderá sobre a hematopoiese, entendendo como são formadas as células sanguíneas das séries vermelha, branca e plaquetária. Essa compreensão é indispensável para reconhecer padrões normais e alterações morfológicas que impactam diretamente o diagnóstico laboratorial.
Outro ponto central da formação é o estudo detalhado da identificação morfológica das células. O aluno será treinado para distinguir eritrócitos, leucócitos e plaquetas, observando características como tamanho, forma, granulações, relação núcleo/citoplasma e alterações sugestivas de patologias. Esse conhecimento é fundamental para a leitura de lâminas e para a construção do laudo hematológico.
Além disso, o curso aborda passo a passo a confecção e coloração do esfregaço sanguíneo, técnica indispensável para um hemograma de qualidade. O aluno aprenderá desde o ângulo correto para espalhamento da gota até o uso adequado de corantes, garantindo uma lâmina homogênea e padronizada.
Com uma abordagem dinâmica e altamente aplicada, este curso apresenta todos os passos que envolvem o hemograma — desde a coleta e manipulação da amostra até a leitura da lâmina e elaboração do laudo inicial.
A proposta é transformar o aluno em um profissional capaz de identificar células, reconhecer padrões normais, detectar alterações morfológicas e realizar contagens com precisão, utilizando técnicas que fazem parte da rotina de qualquer laboratório clínico.

O que você vai aprender:
Ao final do curso, você será capaz de:
Identificar com precisão as células das séries vermelha, branca e plaquetária
Entender todo o processo de formação das células sanguíneas
Produzir um esfregaço sanguíneo de alta qualidade
Realizar corretamente a coloração de lâminas
Diferenciar padrões morfológicos normais e patológicos
Realizar contagem global de leucócitos e plaquetas na câmara de Neubauer
Calcular valores finais de forma correta e segura
Executar a contagem diferencial dos leucócitos
Interpretar achados hematológicos básicos
Relacionar morfologia com possíveis alterações clínicas
Compreender as etapas que levam da amostra ao laudo hematológico
O que inclui a prática do curso:
A parte prática inclui treinamento em contagem global de células pela câmara de Neubauer, técnica essencial para quantificar leucócitos e plaquetas, além da contagem diferencial dos leucócitos, que permite identificar o percentual de cada subpopulação celular.
Este curso foi estruturado para quem busca qualificação profissional rápida, eficiente e de alto impacto, unindo teoria aplicada e prática laboratorial. As vagas são limitadas e o 1º lote já está aberto, garantindo condições especiais para os primeiros inscritos.
Se você deseja dominar as bases da hematologia, interpretar exames com segurança e elevar seu nível profissional, este curso é para você. Inscreva-se agora e dê um passo decisivo rumo à excelência no laboratório clínico.
Contagem Global e Diferencial: Domínio Técnico:
Um dos pilares deste curso é o treinamento na contagem global de células utilizando a Câmara de Neubauer, método clássico e indispensável para:
contagem total de leucócitos
contagem total de plaquetas
verificação de diluições corretas
identificação de erros técnicos
cálculo final por mm³ com precisão
O aluno aprende a preparar as diluições, manipular pipetas e câmaras, reconhecer áreas de contagem e fazer cálculos padronizados.
Também abordamos detalhadamente a contagem diferencial dos leucócitos, realizada na lâmina corada. Esta etapa é essencial para identificar patologias infecciosas, inflamatórias, hematológicas e imunológicas.
O curso ensina o aluno a:
diferenciar as populações leucocitárias
contar 100 células com método sistematizado
registrar porcentagens
interpretar achados como desvio à esquerda, linfocitose reativa, eosinofilia, monocitose e neutropenia
Essas habilidades são indispensáveis para qualquer profissional da área laboratorial.
6. Esfregaço Sanguíneo
Técnica correta
Pontos de erro
Preparação e secagem
7. Coloração do Esfregaço
Panótico
Ajuste de pH
Problemas comuns de coloração
8. Contagem Global
Câmara de Neubauer
Diluições
Técnicas de contagem e cálculos
9. Contagem Diferencial
Contagem de 100 células
Registro e interpretação
Desvios e alterações
DOCENTE:
Dr. Carlos Sales
Carga horária: 10 horas.




